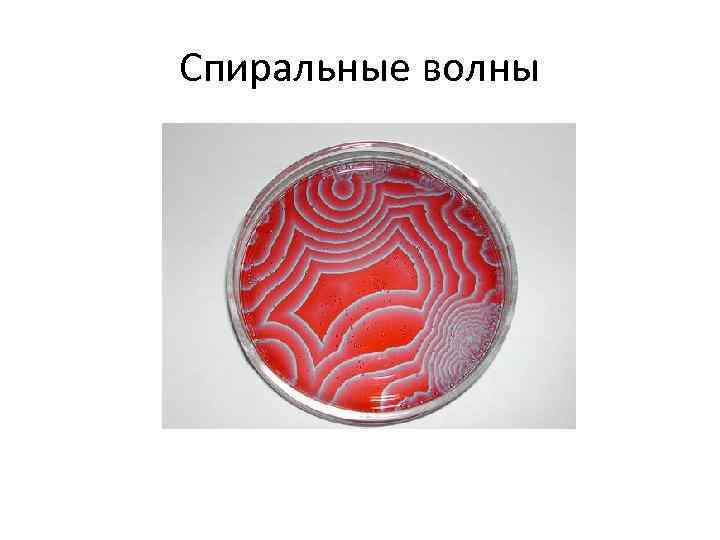
Спиральные волны

8. Порядок и беспорядок в природе - 1.pptx
- Количество слайдов: 61

Раздел «Порядок и беспорядок в природе» Мальцев Алексей Владимирович, Доцент кафедры общей психологии и психологии личности Alexey. Maltsev@urfu. ru

Тема «Динамические и статистические закономерности в природе »

Детерминизм • учение о взаимосвязи и взаимообусловленности происходящих процессов и явлений, доктрина о всеобщей причинности. • Детерминизм (жёсткий) - идея полной предопределённости всех будущих событий

Лаплас 1749 – 1827 гг. Вселенная – скопление атомов. Случай – свойство атомов, которые могут объединяться и отклоняться от своего пути.

Детерминизм "…Мы можем рассматривать настоящее состояние Вселенной как следствие ее прежних состояний и как причину для будущих. Разумное существо, которое могло бы знать в какой -либо момент времени все действующие в природе силы, а также соответствующие положения всех составных частей природы, смогло бы - при наличии достаточных аналитических способностей, для оценки этих данных - охватить движение величайших небесных тел и мельчайших атомов с помощью одной формулы. Ничто не укрылось бы от этого существа; прошедшее и будущее, в равной степени открытые, легли бы перед ним…" Пьер Симон Лаплас (1749 -1827) 5

Динамические научные теории: - описывают состояние системы значениями измеряемых величин, характеризующих систему - позволяют точно рассчитать и однозначно предсказать значения физических величин, характеризующих изучаемую систему, на данный момент времени (на любой момент времени) - не учитывают и не позволяют описывать флуктуации – случайные отклонения системы от наивероятнейшего состояния - не используют аппарат теории вероятности.

Динамическими теориями являются: - механика - электродинамика - термодинамика - теория относительности

Статистические научные теории: - позволяют рассчитывать и предсказывать лишь вероятность того, что величина, характеризующая систему, примет то или иное значение - описывают состояние системы на языке вероятностей, с которыми та или иная величина, характеризующая систему, принимает заданные значения - позволяют точно и однозначно рассчитать средние значения физических величин, характеризующих изучаемую систему - позволяют рассчитать характерную величину флуктуаций случайных отклонений системы от ее наивероятнейшего состояния - учитывают случайные отклонения от нормы - описывают вероятное поведение систем, состоящих из огромного числа элементов.

Вероятностные явления В квантовой физике, физике микромира, мы никогда не знаем состояние системы с точностью большей, чем это допускается принципом неопределенности. Мы вынуждены перейти на вероятностное описание явлений микромира. По яркому выражению Эйнштейна: "…Природа играет в кости…" Заметим, что в природе часто реализуются ситуации, формальная математическая вероятность которых ничтожно мала (пример тому – строение атома, о чем мы говорили ранее) 9

Статистическими теориями являются: - молекулярно-кинетическая теория газов - квантовая механика, другие квантовые теории - эволюционная теория Дарвина - законы наследственности Менделя

Тема «Концепции квантовой механики»

Корпускуля рно-волново й дуали зм Ква нтово-волново й дуали зм — принцип, согласно которому любой физический объект может проявлять как волновые, так и корпускулярные (квантовые) свойства. Например: свет можно трактовать как электромагнитную волну, обладающую явлениями дифракции и интерференции и как поток корпускул (фотонов), которые определяют фотоэлектрический эффект (фотоэффект). Аналогичной способностью обладают элементарные частицы (электрон).

Фотоэлектрический эффект • Появление электрического тока в веществе (металлы) под действием света (или любого другого электромагнитного излучения). • Открыт в 1888— 1890 гг. русским физиком Александром Столетовым. • Фотоэффект был объяснён в 1905 году Альбертом Эйнштейном (за это в 1921 году он получил Нобелевскую премию)

Закономерности фотоэффе кта • Сила фототока прямо пропорциональна плотности светового потока. • Максимальная кинетическая энергия вырываемых светом электронов линейно возрастает с частотой света и не зависит от его интенсивности. • Для каждого вещества существует красная граница фотоэффекта, то есть минимальная частота света (максимальная длина волны - λ), при которой ещё возможен фотоэффект.

Фотоэффект

Объяснение фотоэффекта • В 1900 году М. Планк (1858 – 1947) выдвинул идею, что свет излучается не сплошным "потоком", а порциями. • Этой мельчайшей порции в 1905 г. Планк и Эйнштейн дали название квант (от лат. «quantum» - сколько, как много). 16

Объяснение фотоэффекта • свет излучается только квантованными порциями и существует только в виде квантованных порций в виде частиц (фотонов) • формула Эйнштейна для фотоэффекта: 17

Корпускулярно-волновой дуализм • Луи де Бройль (1892 -1987) (герцог Брольи) показал, что не только фотоны, но и электроны и любые другие частицы обладают как корпускулярными, так и волновыми свойствами. • В 1925 году Эйнштейн писал другу о диссертации де Бройля: "…Прочтите ее! Хотя и кажется, что ее писал сумасшедший, написана она солидно…". 18

Корпускулярно-волновой дуализм • «…Теория света страдала редкой болезнью раздвоения между волновой теорией, с одной стороны, и теорией фотонов - с другой. Чтобы исправить положение, следовало воспользоваться принципом "чем хуже, тем лучше" и перенести эту болезнь на здоровую доселе теорию вещества…". Луи де Бройль 19

Корпускулярно-волновой дуализм На первый взгляд, гипотеза де Бройля (импульс тела mv связан с длиной волны , характеристикой излучения, соответствующей состоянию этого тела, соотношением mv = h, здесь h – постоянная Планка= 6, 6× 10 -38 Дж· c) опровергается повседневным опытом. • В окружающих нас предметах и нас самих нет ничего волнового, однако в микромире эти явления наблюдаются постоянно. 20

Соотношение неопределенностей Гейзенберга • Принципиально нельзя определить одновременно координату и импульс частицы точнее, чем это допускает соотношение неопределенностей. • Этого нельзя сделать точно, так же как нельзя превысить скорость света, достичь абсолютного нуля температур, поднять себя за волосы, вернуть вчерашний день. 1901 – 1976 гг.

Мысленный эксперимент «микроскоп Гейзенберга» Мысленный эксперимент: чтобы точно определить положение электрона в пространстве, необходимо направить на него электромагнитную волну, «осветить» его и посмотреть в некий сверхсильный «микроскоп» . Но при этом сам микрообъект (например, электрон), являющийся объектом излучения, в результате взаимодействия, с направленным на него другим микрообъектом (квантом света – фотоном), изменит свое положение в пространстве. Таким образом, сам факт замера приводит к изменению положения измеряемого объекта, и неточность измерения обуславливается самим фактом проведения измерения, а не степенью точности используемого измерительного прибора.

Принцип относительности к средствам наблюдения. • Ранее считалось, что устройство мира можно познавать, не вмешиваясь в него, не влияя на протекающие в нем процессы. Эйнштейн не включал в понятие «физическая реальность» акт наблюдения, а Бор считал его важным элементом физической реальности. • Картина реальности в квантовой механике становится как бы двуплановой: с одной стороны в нее входят характеристики исследуемого объекта, а с другой – условия наблюдения.

Принцип дополнительности Нильса Бора (1927 г. ) • «Как бы далеко не выходили явления за рамки классического физического объяснения, все опытные данные должны описываться при помощи классических понятий • Для полного описания квантово-механических явлений необходимо применять два взаимоисключающих (дополнительных) набора классических понятий, совокупность которых дает наиболее полную информацию об этих явлениях как о целостных (координата и импульс, энергия и время)»

Современная трактовка принципа дополнительности • Всякое истинное явление природы не может быть определено однозначно с помощью слов нашего языка и требует для своего определения, по крайней мере, двух взаимоисключающих дополнительных понятий. К числу таких явлений относятся, например, квантовые явления, жизнь, психика и др.

Статистический характер квантового описания природы Из-за принципа неопределенностей, описание объектов квантового микромира носит иной характер, нежели привычное описание объектов ньютоновского макромира. Вместо пространственных координат и скорости, которыми привыкли описывать механическое движение, в квантовой механике объекты описываются, так называемой, волновой функцией. Гребень «волны» соответствует максимальной вероятности нахождения частицы в пространстве в момент измерения. Движение такой волны описывается уравнением Шрёдингера, которое и говорит нам, как изменяется со временем состояние квантовой системы.

Волновая функция


Решения уравнения Шредингера

Тема «Принцип возрастания энтропии»

Виды энергии • Потенциальная (положения) • Кинетическая (движения) • Диссипации (рассеяния)

Формы энергии: Низкокачественные: -тепловая(энергия беспорядочного движения молекул и атомов) Высококачественные: -механическая (энергия движения макроскопических тел) -электрическая(энергия возникшая в результате движения электронов между атомами) -химическая(энергия, вызываемая движением электронов внутри атомов) -ядерная или атомная (энергия обусловленная взаимодействиями внутри атомов и ядер атомов)

Вечный двигатель • Вечный двигатель первого рода - воображаемая машина, которая будучи раз запущена в ход, совершала бы работу неограниченно долгое время, не заимствуя энергию извне. • Вечный двигатель второго рода - воображаемая машина, которая целиком превращала бы в работу теплоту, извлекаемую ею из окружающих тел.

Первый закон термодинамики – закон сохранения энергии при ее превращениях. • Количество теплоты, сообщенное телу, идет на увеличение его внутренней энергии и на совершение телом работы над внешними телами: d. Q = d. U + d. A или • Изменение внутренней энергии тела равно разности сообщенного телу количества теплоты и произведенной над ним механической работы: d. U = d. Q - d. A

Второй закон термодинамики как принцип направленности теплообмена (от горячего к холодному). • Постулат Клаузиуса: Теплота не может сама собой переходить от тела с более низкой температурой к телу с более высокой температурой. • Второе начало термодинамики определяет направление процессов, происходящих в природе и связанных с превращением энергии.

Второй закон термодинамики (1) • Превращение теплоты в работу возможно только при наличии нагревателя и холодильника; • Во всех тепловых машинах полезно используется только часть энергии, передаваемая от нагревателя к холодильнику (то есть ни один тепловой двигатель не может дать КПД, равный 100%).

Энтропия как мера молекулярного беспорядка • Энтропия - функция, характеризующая направление протекания самопроизвольных процессов в замкнутой термодинамической системе. • энтропия выражает способность энергии к превращениям: чем больше энтропия системы, тем меньше заключенная в ней энергия способна к превращениям. • Закон возрастания энтропии, или второе начало термодинамики, определяющее направление энергетических превращений: в замкнутой системе энтропия не может убывать, а может либо сохраняться либо возрастать. d. Q/T = d. S Единица энтропии – джоуль на кельвин (Дж/К).

Второй закон термодинамики как принцип нарастания беспорядка и разрушения структур (2) • «При прохождении в изолированной системе самопроизвольных процессов энтропия системы возрастает» • Примеры: – таяние льда – превращение жидкой воды в пар

Второе начало термодинамики- закон рассеяния энергии (3) • Неприменимо к открытым системам • В открытых системах энтропия может, как увеличиваться - при подводе тепла извне, так и уменьшаться - при теплоотдаче в окружающую среду • Пример – живые организмы, которым требуется постоянный приток извне веществ и энергии, а также отвод во внешнюю среду тепла и продуктов распада (обмен веществ и энергии).

Тема «Закономерности самоорганизации. Принципы универсального эволюционизма»

Синергетика – теория самоорганизации. • Синергетика – наука об универсальных свойствах явлений самоорганизации в динамических неравновесных системах. • Cинергетика – междисциплинарное направление научных исследований, задачей которого является изучение природных явлений и процессов на основе принципов самоорганизации систем (состоящих из подсистем).

Cамоорганизация • Любое усложнение временной, пространственной или функциональной внутренней структуры сложной открытой системы в процессе эволюции, происходящее по правилам внутренней функциональной среды, присущим данной системе, без специфического воздействия из вне.

Основоположники синергетики • И. Пригожин - бельгийский физик и химик лауреата Нобелевской премии 1977 г. , • Г. Хакен, М. Эйген - немецкие физики • Б. Белоусов и А. Жаботинский советские химики.

Ячейки Бернара возникновение упорядоченности в виде ячеек в форме цилиндрических валов или правильных шестигранных структур в слое вязкой жидкости, равномерно подогреваемой снизу 44

Реакция Белоусова-Жаботинского Класс химических реакций, протекающих в колебательном режиме, при котором некоторые параметры реакции (цвет, концентрация компонентов, температура и др. ) изменяются периодически. 45
Спиральные волны

Необходимые условия самоорганизации • Неравновесность системы • Нелинейность системы

Равновесные системы • Системы длительно время могут находится в неизменном состоянии. Энтропия максимальна. • Элементы системы действуют неограниченно "свободно", независимо от влияния других элементов. В системе отсутствует какая-либо упорядоченность.

Неравновесные системы • В системе постоянно происходят изменения • Элементы системы взаимно влияют друг на друга • Энтропия таких систем минимальна и может уменьшаться • В структуре системы имеет место упорядочённость

Нелинейность системы • Структура системы разветвлена • Процессы чаще всего происходят по волновому принципу • В отличие от линейной системы НЕ обладает свойствами суперпозиции

Диссипация (рассеяние) энергии в неравновесной системе. • Переход части энергии упорядоченных процессов (кинетической энергии движущегося тела, энергии электрического тока) в энергию неупорядоченных процессов, в конечном счете – в теплоту. • Системы, в которых энергия упорядоченного движения с течением времени убывает за счет диссипации, переходя в другие виды энергии, например в теплоту или излучение, называются диссипативными.

Диссипативная структура • неравновесная упорядоченная структура, возникшая в результате самоорганизации • условия образования диссипативных структур: – система является термодинамически открытой – отклонение от равновесия превышает критическое значение – динамические уравнения системы не линейны – микроскопические процессы происходят кооперативно

Точка бифуркации • Критическое состояние системы, при котором система становится неустойчивой относительно флуктуаций и возникает неопределенность: станет ли состояние системы хаотическим или она перейдет на новый, более дифференцированный и высокий уровень упорядоченности • В точке бифуркации эволюционный путь системы разветвляется, в каком направлении пойдет развитие – не известно.

Снижение пространственной симметрии в точке бифуркации • Снижение симметрии порождает более высокую упорядоченность и, следовательно, снижает энтропию системы. • Эволюция есть последовательное образование диссипативных структур в состояниях, далеких от термодинамического равновесия. (Неравновесность есть то, что порождает порядок из хаоса. ) • Несмотря на повышение в процессе саморазвития уровня организации и сложности систем, с течением времени происходит ускорение эволюции.

Синхронизация частей системы в процессе самоорганизации • В точках бифуркации перед самоорганизующейся системой открывается множество вариантов (поле) путей развития. Одновременно возникает множество диссипативных динамических микроструктур - прообразов будущих состояний системы – фракталов • В точке бифуркации происходит своеобразная конкуренция фракталов, осуществляется их «отбор» . В результате конкуренции происходит самопроизвольный выбор той структуры, которая наиболее адаптивна к сложившимся на данный момент внешним и внутренним условиям.

Синхронизация частей системы в процессе самоорганизации • Флуктуации возникают хаотично, их огромное количество, но большинство из них затухает, остаются только те, которые образуют новые устойчивые макросостояния (структуры) - аттракторы. • Аттрактор как бы притягивает к себе множество траекторий развития системы, определяемых разными начальными значениями параметров, создавая своеобразный конус.

Фрактальность кривой Х. Кох (1870 -1924) 57

Снежинка Коха • Итальянский математик Э. Чезаро (1859 -1906), удивленный внутренней бесконечностью и самоподобием снежинки Кох, писал в 1905 году: «Если бы она была одарена жизнью, то можно было бы лишить ее жизни, только уничтожив кривую в целом, в противном случае она возрождалась бы снова из глубины своих треугольников, как это делает жизнь во Вселенной» . 58

Изменение энтропии при самоорганизации • Понижение энтропии системы • Повышение энтропии окружающей среды


Универсальный эволюционизм как научная программа современности • всё существует в развитии; • развитие - чередование медленных количественных и быстрых качественных изменений (бифуркаций); • законы природы это принципы отбора допустимых состояний из всех мыслимых; • фундаментальная и неустранимая роль случайности и неопределенности; • непредсказуемость пути выхода из точки бифуркации (прошлое влияет на будущее, но не определяет его); • устойчивость и надежность природных систем как результат их постоянного обновления
8. Порядок и беспорядок в природе - 1.pptx